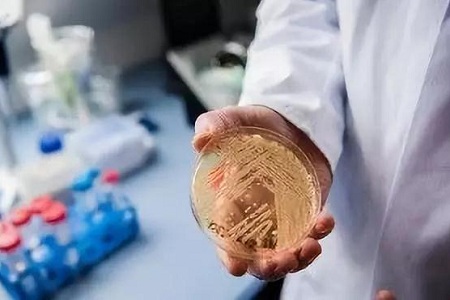

耳念珠菌在美国爆发,患病死亡率超过60%
耳念珠菌在美国爆发,患病死亡率超过60%,根据海外的CBS新闻,我们知道社会正被一种名为耳念珠菌的真菌困扰着,在美国还爆发了超过60%的死亡率,而在国内也已经确诊18个案例,可想而知我们离这个可怕的真菌有多远。
根据海外的CBS新闻,我们知道社会正被一种名为耳念珠菌的真菌困扰着,在美国还爆发了超过60%的死亡率,而在国内也已经确诊18个案例,可想而知我们离这个可怕的真菌有多远。
据悉被这个真菌感染的患者,近50%的患者会在90天之内身亡,它会引发高烧病症,随后又会逐渐出现器官衰竭、呼吸衰竭等。所以当我们看到这个可怕的消息后,朋友圈简直就被这段视频刷爆了,满满都是危机既视感。
果然,人类在不停前进的同时细菌、真菌也在不断进步。只是小编希望大家不要只看新闻的一面之词,不然没病都会被吓出病来。据了解,耳念珠真菌对于的人群并不会造成特别大的影响,因此健康的人就不用过于担心害怕了。不过由于它感染的是那些免疫力低下的人群,特别是ICU病房中的患者,所以身体比较虚弱的人在生活中就需要多注意了,应该提高自身的免疫能力,只有这样自己才不容易受耳念珠真菌的感染。

其实,不管是中医说的风邪、寒邪以及湿邪等,还是西医中提到的细菌、真菌、病毒等,对于身体免疫力好的人来说,从来都是井水不犯河水,只是在生活中若我们的机体免疫能力不足,那么过敏、感冒、咳嗽、发烧等便会随之而来。

而在这个入侵者无处不在的社会中,特别是病毒、细菌活跃频繁的春季里,我们若是不提高自己的免疫系统,就真的特别容易出事。想必大家现在也还记得03年的非典、15年的骆驼病,以及17年的诺如病毒,实际上都是春天引发的。那么病毒为什么会容易在春天爆发呢?主要原因还是水与风。由于水是生命之源,因此在温度适宜的条件下病毒繁殖就更快,又由于春主风而风是万病的开始,所以其危害就更大。
本文《耳念珠菌在美国爆发,患病死亡率超过60%》禁止任何网站进行转载!
免责申明:以上内容属作者个人观点,版权归原作者所有,不代表恩施知识网立场!登载此文只为提供信息参考,并不用于任何商业目的。如有侵权或内容不符,请联系我们处理,谢谢合作!
当前文章地址:https://www.esly.wang/jiankang/221287.html 感谢你把文章分享给有需要的朋友!

文章评论